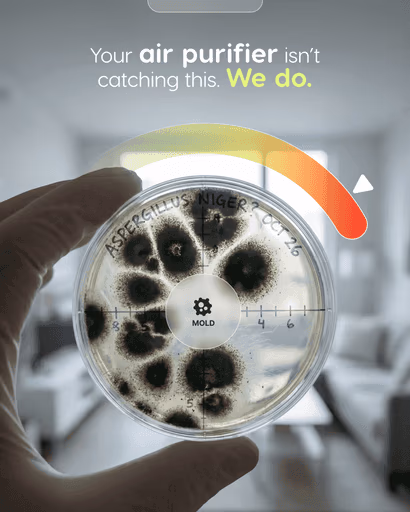
Portfolio piece 17

AI Powered,
Undeniably Human
AI-Governed Growth Engine
AI Powered,
Undeniably Human
AI-Governed
Growth Engine













International Leadership Convention
A curated collection of projects designed with care


Nu Dentistry
We built everything — brand identity, marketing strategy, SEO architecture, and patient acquisition systems from the ground up. In 2020, we constructed their first practice and marketed them through the height of COVID. Six offices and counting — with the latest opening in March 2026. AI scales their content pipeline — Monarchy still drives the brand, the strategy, and the creative.


Wanted Fertility
We didn’t just brand Wanted Fertility — we built it. From concept to name to visual identity to patient journey, this is a Monarchy-created brand. The science of a decision-based protocol — giving women back control of their fertility journey with clarity. Root-cause protocol first. IVF as a last resort, not a starting point.


AI X Factor
AI X Factor is a 3-day live event with one promise: 5x sales appointments, 10x leads, 100x content — in 72 hours. Monarchy partnered on the marketing engine. Every event clears $600K in gross revenue.


BYTR
BYTR is AI-designed, robot-milled dental reconstruction — same-day full-arch smiles, engineered precision, multi-location. Monarchy built the launch stack from day one: brand, video, before-and-after assets, landing pages, ad creatives, and the full acquisition funnel. By the time the doors opened, the funnel was already running.


The Chiro Guy
We built a social media strategy around Dr. Ash’s Beverly Hills setting, high-touch service, and on-camera presence. AI-powered content analysis identified the angles that resonated. Results: 500%+ organic traffic growth on TikTok. The content now drives new patients before they ever Google him.
Monarchy is the perfect fit for fast moving brands
Validated by the world's most respected business rankings
Game Changers Fest
Andrea d’Agostini received the Game Changers Award in November 2021 for his work as an entrepreneur and humanitarian.
Game Changers Fest
Andrea d’Agostini received the Game Changers Award in November 2021 for his work as an entrepreneur and humanitarian.












Answers to common questions
Book a Growth Call. 30 minutes, no pitch deck. We learn your business, identify the gaps, and tell you exactly where AI can move the needle. If there’s a fit, we move into Discovery.
AI powers speed and scale. Humans power strategy, creative direction, and brand voice. Your brand identity is built entirely by our human team — AI never touches your core identity. Everything AI produces is governed by that identity system. That’s the “Undeniably Human” part.
Our founder scaled a company from $24M to $386M. We’ve served 2,000+ clients, managed $1B+ in campaigns, and made the Inc. 5000 two years running. We were building growth systems before AI was a headline — and we’ll be here long after the hype cycle ends.
We can. But strategy without execution is a PDF. Execution without strategy is expensive guessing. The power is in the system — AI execution governed by human strategy.
ChatGPT without a brand system, conversion architecture, and strategic direction produces generic output. We’re not selling AI access. We’re selling the intelligence layer that makes AI output actually convert — the judgment, the brand governance, the decade of scaling experience.
Because AI multiplied what our team can do. Work that used to require 8 specialists now takes 3 people plus AI systems. We pass that efficiency to you. It’s not “cheap” — it’s structurally more efficient.
Our AI voice agents operate at sub-second latency — callers can’t tell the difference. But here’s the thing: if a call gets complex, a human takes over. That’s not a backup plan. That’s the design.
Discovery: 2–3 weeks. Build: 3–4 weeks. AI call center goes live in week one. Lead gen shows movement within 60 days. SEO compounds over 90–180 days.
Service businesses, professional practices, and product brands past $500K. Whether you’re starting from zero with AI or you’ve already experimented and want it done right — we should talk.
Marketing insights,
minus the noise
Tactics, trends, and fixes that actually ship.